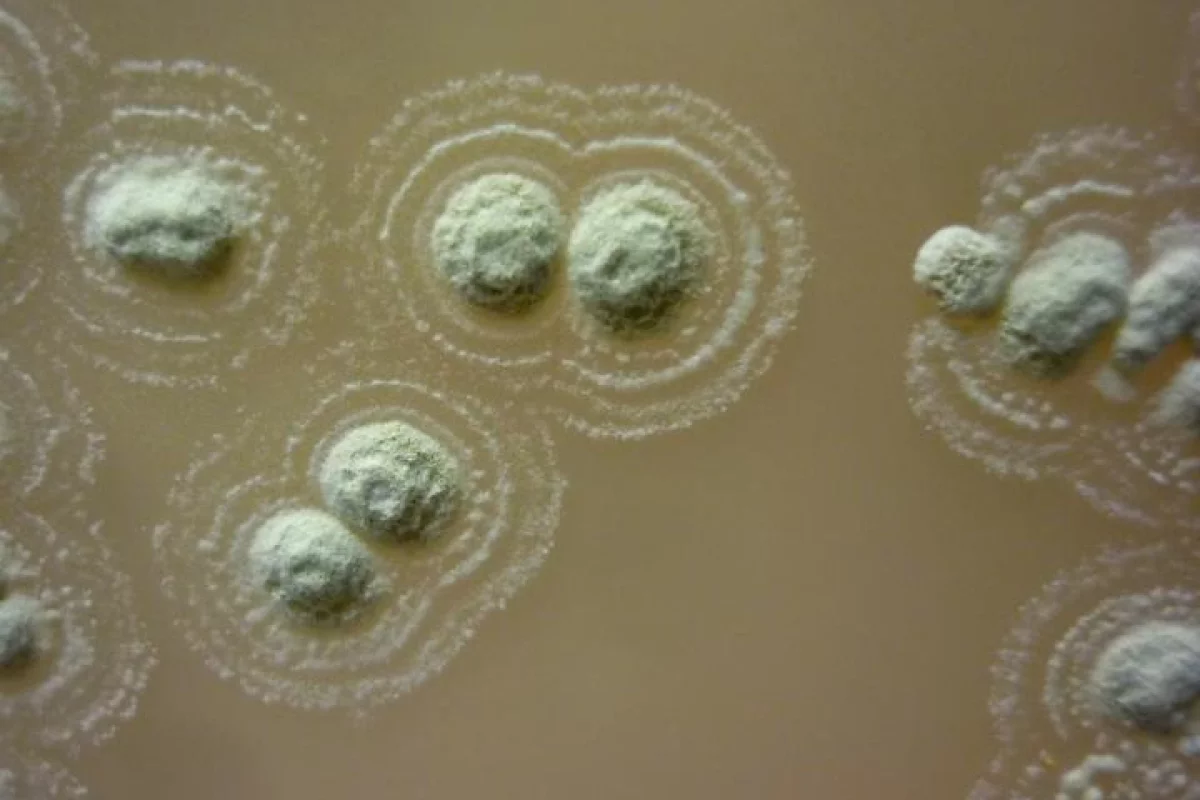
The newly-discovered bacteria strain Streptomyces sp. myrophorea, which has been found to produce potent antibiotics

For the past century or so, we've been able to kill bacteria with relative ease, thanks to antibiotics. But the bugs are adapting to them, leading scientists into an arms race to keep us from being plunged back into the "dark ages of medicine." But it turns out, looking to the past might help our future – a team of researchers from Swansea University Medical School has discovered a new potential superbug killer in Irish soil, which has long been believed to have healing properties.
According to local lore, the soil in the Boho Highlands in Fermanagh, Northern Ireland, could help cure what ails ya. Thousands of years ago, the soil was used to treat things like toothache and infections. These kinds of folk medicines might not get much attention in the scientific community nowadays, but with the looming threat of antibiotic-resistant bacteria, more researchers are investigating whether the old stories have any truth to them.
The Swansea team tested soil from the Boho Highlands area, looking for signs of the presence of Streptomyces bacteria, which are well known for producing antibiotics. And find them they did, including a brand new strain of the bug that has now been named Streptomyces sp. myrophorea.
This new strain was found to be effective at killing several pathogens on the World Health Organization's priority list. This includes carbapenem-resistant Acinetobacter baumannii, which is listed as critically threatening; Vancomycin-resistant Enterococcus faecium (VRE) and methicillin-resistant Staphylococcus aureus (MRSA), both of which are of high priority on the list; and Klebsiella pneumonia. Interestingly, this new Streptomyces strain was found to inhibit both gram positive and gram negative bacteria, with the latter generally being trickier to kill.
"The discovery of antimicrobial substances from Streptomyces sp.myrophorea will help in our search for new drugs to treat multi-resistant bacteria, the cause of many dangerous and lethal infections," says Gerry Quinn. "We will now concentrate on the purification and identification of these antibiotics. We have also discovered additional antibacterial organisms from the same soil cure which may cover a broader spectrum of multi-resistant pathogens."
The superbug problem may be alarming, with news that even our last resort antibiotics are beginning to fail, but there is hope. This Irish highlands soil joins a growing list of strange places that potential treatments have been found in recent years, with others including platypus milk, tobacco flowers, rattlesnake venom, human breast milk, honey, maple syrup, and frog skin.
The research was published in the journal Frontiers in Microbiology.
Source: Swansea University via Science Daily